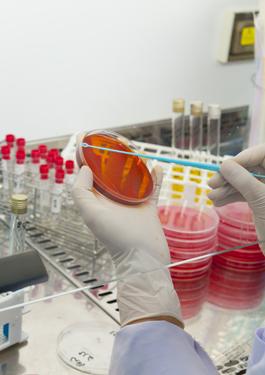
food laboratory testing

CERTIFICATION
Food
certifications
Food certification allows you adopting the highest standards in food safety, meeting your regulatory requirements and your contractual obligations and gaining access to global markets.
BUSINESS CHALLENGES
- Ensure safety & demonstrate the quality of your product
- Protect your brand by controlling safety throughout your supply chain
- Demonstrate the high value of your products through product certification
OUR CERTIFICATIONS
ISO 22000: Developing a robust food safety management system that promotes continuous improvement of all processes that impact on the safety of finished food products. Read more
FSSC 22000: risk management system for food safety throughout the food supply chain
HACCP: Hazard Analysis Critical Control Point. Standard to ensure that food is safe at the time of human consumption
HALAL: Guarantees that products and services aimed at Muslim population meet the requirements of Islamic law